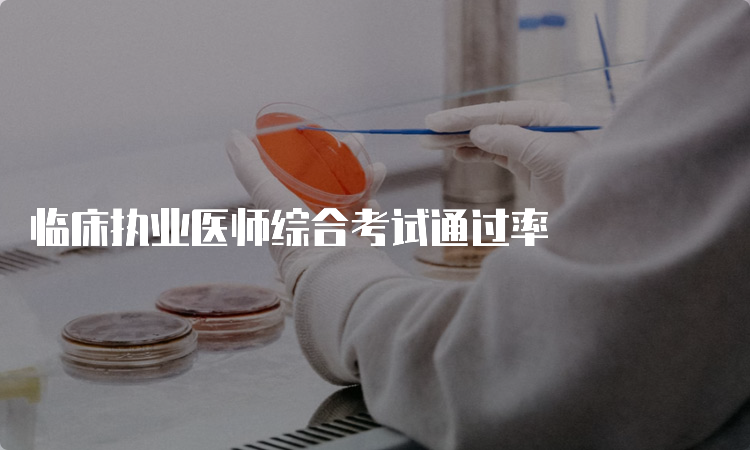

2023兵团临床执业医师技能考试形式是什么

2023青海临床执业医师实践技能考试流程是什么

临床执业医师刷题通过率

2023湖北临床执业医师技能考试形式是什么

2023年临床执业医师考试总分多少

临床执业医师笔试通过率多少

2023年临床执业医师考试总分多少分

2023年临床执业医师资格证指南

2023新疆临床执业医师技能考试流程是什么

2023年零基础临床执业医师如何备考

临床医学毕业考取执业医师比率

2023青海临床执业医师技能考试形式是什么

临床执业医师资格笔试通过率
临床执业医师综合考试通过率

2023临床执业医师资格考试指南